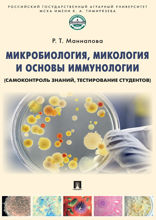
Микробиология, микология и основы иммунологии (самоконтроль знаний, тестирование студентов). Учебное пособие

Ветеринария
КИОН Строки
Сервис для чтения: книги, подкасты, аудиокниги и многое другое.
Читайте онлайн и офлайн.
© 2026 ООО «Строки». Все права защищены.18+5.55.0
Сервис для чтения: книги, подкасты, аудиокниги и многое другое.
Читайте онлайн и офлайн.